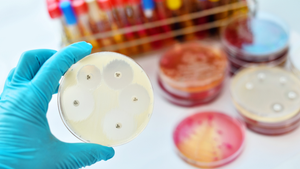

Navigating the complexities of fibromyalgia
Advanced assessment tools and digital health applications help identify effective treatment strategies for fibromyalgia patients.
October 17, 2023

Fibromyalgia, a complex and debilitating chronic pain disorder, is underdiagnosed despite its global impact. The rising incidence of fibromyalgia can be attributed to various factors, such as limited medical awareness, evolving diagnosis criteria, ongoing research progress, and the influence of environmental factors. This underscores the urgent need to address the significant gaps in its treatment options. The fibromyalgia treatment market presents both challenges and opportunities that require immediate attention.
The fibromyalgia treatment landscape
Fibromyalgia is often misunderstood and misdiagnosed. It is characterised by widespread pain, fatigue, sleep disturbances, and cognitive dysfunction. This challenging condition presents complex symptoms that baffle medical professionals and researchers. It involves pain that extends beyond typical physical boundaries, resulting in pervasive discomfort without clear explanations. This discomfort is frequently coupled with profound fatigue, making everyday tasks a challenge, and significantly impacting the lives of those living with it.
Related: Grasping the economic cost of chronic pain
Patients and healthcare experts face the ongoing challenge of managing its symptoms. Researchers continue their diligent efforts to explore potential treatments and better understand the condition, offering hope for improved quality of life.
Personalised treatment: the need of the hour
One size does not fit all when it comes to fibromyalgia treatment. Each patient's condition experience is unique, and what works for one individual may not be effective for another. This calls for a personalised treatment approach considering the patient's specific symptoms, lifestyle, and preferences. Personalisation in fibromyalgia treatment entails customising interventions, whether pharmaceutical, lifestyle-based, or alternative therapies, to suit each patient. Advances in technology, such as assessment tools and digital health applications, offer promising prospects for identifying the most effective treatment strategies for each patient.
However, developing personalised treatment options for fibromyalgia comes with challenges. Research in this field is still in its infancy, and comprehensive data and standardised diagnostic criteria are lacking. Investors willing to support the development of personalised solutions must navigate this uncertainty, making it a challenging venture.
Investor challenges: technical and financial
Investing in the fibromyalgia treatment market requires a realistic understanding of the significant challenges involved. From a technical perspective, the challenges are quite complex. They involve the need for well-designed and meticulously conducted clinical trials, pinpointing specific factors that can customise treatments for individual patients and creating innovative therapies that can effectively tackle the varied symptoms of Fibromyalgia. Since the condition varies from person to person, finding a universal "one-size-fits-all" treatment is difficult, requiring a thorough and personalised approach that considers each patient's distinct requirements and reactions.
Additionally, investors often struggle with the need for significant funding to support research and development efforts for Fibromyalgia treatments. This financial burden is compounded by the limited awareness and persistent stigma associated with the condition, making attracting investment capital quite challenging. Moreover, the protracted nature of clinical trials, often spanning several years, and their inherently unpredictable outcomes may discourage those investors from seeking swift returns on their investments.
Related: World Arthritis Day highlights innovative treatments
Considering these multifaceted challenges, investors keen on making a meaningful impact in this critical area of healthcare must consider fostering collaborations between researchers, healthcare providers, and technology enterprises. Such partnerships can lead to more comprehensive and data-driven approaches to understanding and treating fibromyalgia. Additionally, advocating for governmental support through grants and incentives is vital, as these measures can stimulate more significant investment in the pursuit of effective fibromyalgia treatments, ultimately benefitting both patients and the broader healthcare ecosystem.
Expanding insurance coverage for fibromyalgia treatments
Insurance coverage for fibromyalgia treatments is another pressing issue. Many insurance plans worldwide cover only a limited range of pharmaceutical or injection-based treatments. This narrow approach can leave patients without access to alternative, often more effective treatments.
One example of such an emerging treatment is Hyperbaric Oxygen Therapy. Some studies have suggested that HBOT can provide significant symptom relief for fibromyalgia patients. However, the cost of HBOT sessions for treating Fibromyalgia is currently not covered by insurance, leaving many patients unable to afford this potentially life-changing treatment.
There is a need for insurance reform to ensure that fibromyalgia patients have access to a broader range of treatments. This reform should also address the financial burden on patients, who often must pay out of pocket for treatments not covered by insurance.
A multidisciplinary approach to fibromyalgia care
In addition to personalised treatments and expanded insurance coverage, a multidisciplinary approach to fibromyalgia care is essential. Fibromyalgia is not just about physical pain; it also affects mental health. Psychological support services, such as therapy and counselling, should be integral to the treatment plan.
Fibromyalgia patients often struggle with depression, anxiety, and the psychological impact of living with a chronic condition. Providing access to mental health professionals who understand the unique challenges of fibromyalgia can significantly improve patients' overall well-being and treatment outcomes.
Employers are pivotal in influencing the well-being of individuals with fibromyalgia. Employers can provide valuable support by offering flexible work arrangements, such as remote work options, or by creating comfortable work environments that accommodate the unique needs of employees with fibromyalgia. Addressing sick leave policies to accommodate flare-ups and the condition's unpredictability is also crucial. However, when employers fail to provide such support, it can perpetuate a detrimental cycle.
Without the necessary workplace accommodations, individuals may face difficulties accessing costly treatments, resulting in worsened symptoms, increased mental health challenges, heightened pain, and reduced quality of life. Therefore, fostering a supportive work environment is essential in alleviating the burden of fibromyalgia for affected individuals.

Dr. Mouzayan Ginzarly is a Family Medicine Consultant at Aviv Clinics Dubai.
Get the latest insights from the healthcare industry straight to your inbox. Subscribe for a bi-weekly roundup of the latest healthcare tech, trends, innovation and patient experience, accompanied by exclusive interviews from the industry’s leaders.
___